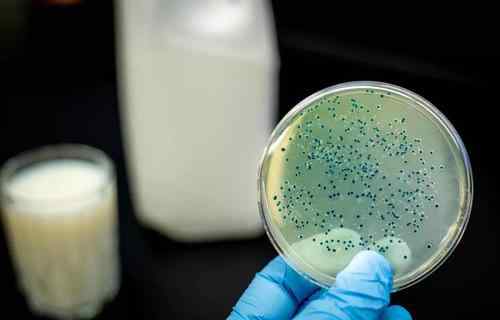

在中国爆发的同时,尼日利亚爆发了新一轮的拉沙热。
2020年以来,尼日利亚发现疑似病例1708例,确诊病例472例,死亡70例。
到目前为止,中国还没有拉沙热的病例报告,所以这种病毒可能我们并不熟悉。
但是,一个非常简单的描述就能让你知道拉沙热病毒的恐怖——
与埃博拉病毒一起,是生物安全级别最高的4级病毒,已被WHO确定为未来最有可能爆发的病毒之一。
蓝色:一个继续蔓延的国家
格林:几个案例
灰色:未知
这个消息一出来,很多人都有点恍惚。尼日利亚不是刚确认是化学药剂吗?
其实这是两件事。
2月7日,尼日利亚政府警告了这起化学事件。
2月7日,尼日利亚政府警告称,该国爆发了一种未知疾病,患者会出现呕吐、腹泻、肿胀等症状。
这种疾病席卷了19个州,造成47人死亡,365人感染,许多人在发病后48小时内死亡。
当时尼日利亚政府惊慌失措,立即检测疾病是埃博拉还是拉沙热,结果没有。
这个消息是11日传入中国的,但结果也是当天传来的:经WHO初步调查,可以排除病毒和细菌感染的可能性,推测是农药中毒。
专家推测,通过某些化学物质捕鱼是可能的,人吃了会中毒。
当时,许多人觉得农药中毒虽然是一场悲剧,但就传染性而言,幸运的是...幸运的是,它不是一种传染性很强的拉沙热。
否则,以尼日利亚的卫生状况,全国甚至很难出现拉沙热...
但事实上,尼日利亚的拉沙热病毒已经爆发...
让我们来介绍拉沙出血热(LHF)。
这是一种由拉沙病毒引起的出血热。
急性,传染性强,连拉沙热最著名的权威专家孔特也死于此病。
我们可能很少听说这种病毒,因为拉沙热是由啮齿动物传播的,中国的啮齿动物从未检测到拉沙热病毒。
换句话说,离得远对我们威胁不大。
这种病毒真正威胁的宿主是乳鼠、纳塔鹿茸鼠或西非的非洲鼠。
这可能是赤道非洲最常见的老鼠,分布在整个非洲大陆的西部、中部和东部。
它能快速繁殖大量后代,喜欢生活在人类聚居区。在人类家中非常常见,甚至在一些地区作为美味的食物食用。
从源头控制拉沙热是完全不切实际的。
更可怕的是感染了拉沙热病毒的老鼠不能死。
但是,它会在余生通过粪便和尿液排出病毒。
不要说摸老鼠本身,就算摸了被污染的谷仓,也有可能接触到病毒。
拉沙热最著名的宣传材料之一明确指出“触摸、玩耍或处理老鼠尸体可能会导致你患上拉沙热。”
除了来源不可控,病毒也很狡猾。
如果有人接触到病毒并被感染,它不会立即攻击。
一周前,你几乎没有任何反应,病毒悄悄潜伏在你体内。
一周后,它开始爆炸。
有些人在第6天出现症状,大多数死亡发生在第14天。
但是过了两周就不要觉得安全了。有些人...直到21天才出现症状。
拉沙热的症状让医生头疼。
它的临床症状...几乎可以说,除了发烧,出血,还有各种症状。
病人开始发烧、咳嗽、虚弱、恶心和呕吐,全身疼痛。
患者口腔、牙龈、胃肠道开始出血,开始出现低血压,呼吸困难。
四分之一的幸存者会有听力损失甚至耳聋。
但是你应该注意到这些症状...真的很常见!
因此,拉沙热很难根据症状进行诊断,病毒RNA必须通过实验室检测才能真正确诊。
但是.....在西非的医疗条件下,不是每个病人都能找到可以立即测试的设备。
这时,又出现了另一个问题。
拉沙热病毒的传播途径是什么?气雾剂!
是的,气溶胶除了接触病人或病人接触过的物体外,还会引起传播。
因此,一旦早期没有得到足够的重视,医务人员也有可能造成感染...
和SARS-CoV-2一样,医护人员在接触拉沙热患者时必须戴手套、口罩、实验服和护目镜,否则有感染的风险。
因此,当拉沙热爆发时,他们也需要大量的医疗用品。
但是...根据2017年的数据,尼日利亚的医疗防护产品生产公司屈指可数。
他们的医疗产品大部分是进口的,甚至是从中国进口的。
另一方面,虽然拉沙热已经发现了70年,但人类直到现在仍然没有疫苗。
所有的临床治疗都只是“对症下药”,换句话说,发烧时吃退烧药,脱水时补水,只改善症状。
虽然有推荐的抗病毒药物,但是可以降低死亡率。然而,支持其有效性的证据仍然很薄弱,甚至在某些情况下,它会恶化结果。
死亡率方面,拉沙热住院患者中约有15%会死于此病。
不过这是在医疗资源充足的情况下。
如果拉沙热真的爆发,成为流行病,其死亡率可能高达50%。
这次疫情,尼日利亚政府可以说是忧心忡忡。
从1969年在尼日利亚的莎拉镇发现这种病毒开始,这个国家有太多关于血和泪的记忆了。
近年来,由于医疗卫生条件和疾病控制系统薄弱,尼日利亚几乎每年都发生拉沙热。
这次尼日利亚同时在26个州爆发,很可能成为有史以来最大规模的拉沙热爆发。
看到这些天灾人祸,我的心很沉重,但现在我们已经没有余力支撑了。
2020年开学真的太难了...
希望世界快点好起来,希望大家平安。
https://www . who . int/zh/news-room/facts-sheets/detail/Lassa-heart
1.《拉沙热病毒 472确诊70死亡!尼日利亚拉沙热恐成有记录以来最大爆发…》援引自互联网,旨在传递更多网络信息知识,仅代表作者本人观点,与本网站无关,侵删请联系页脚下方联系方式。
2.《拉沙热病毒 472确诊70死亡!尼日利亚拉沙热恐成有记录以来最大爆发…》仅供读者参考,本网站未对该内容进行证实,对其原创性、真实性、完整性、及时性不作任何保证。
3.文章转载时请保留本站内容来源地址,https://www.lu-xu.com/keji/1274804.html